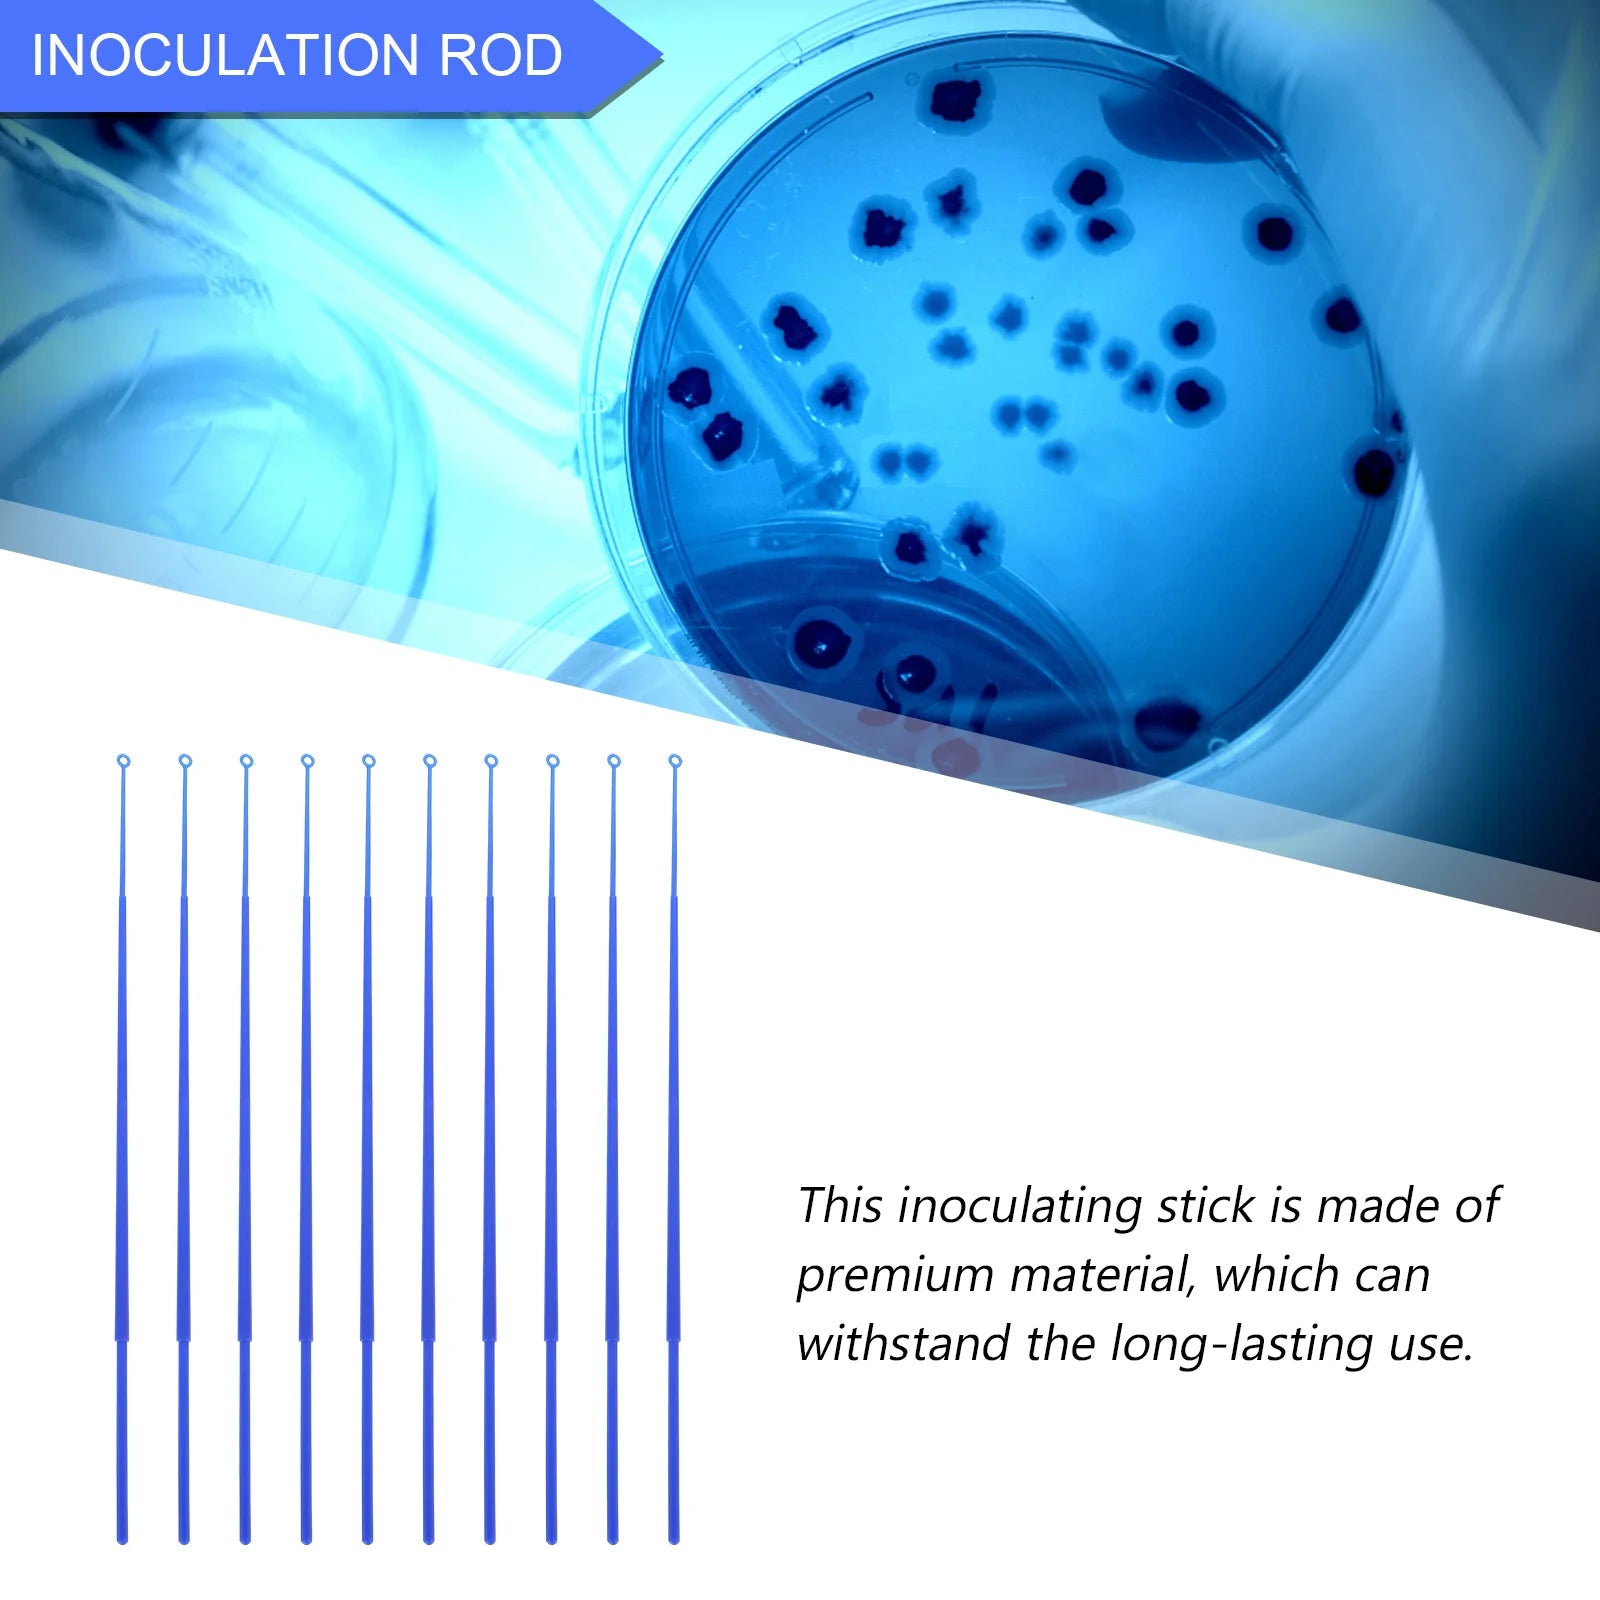
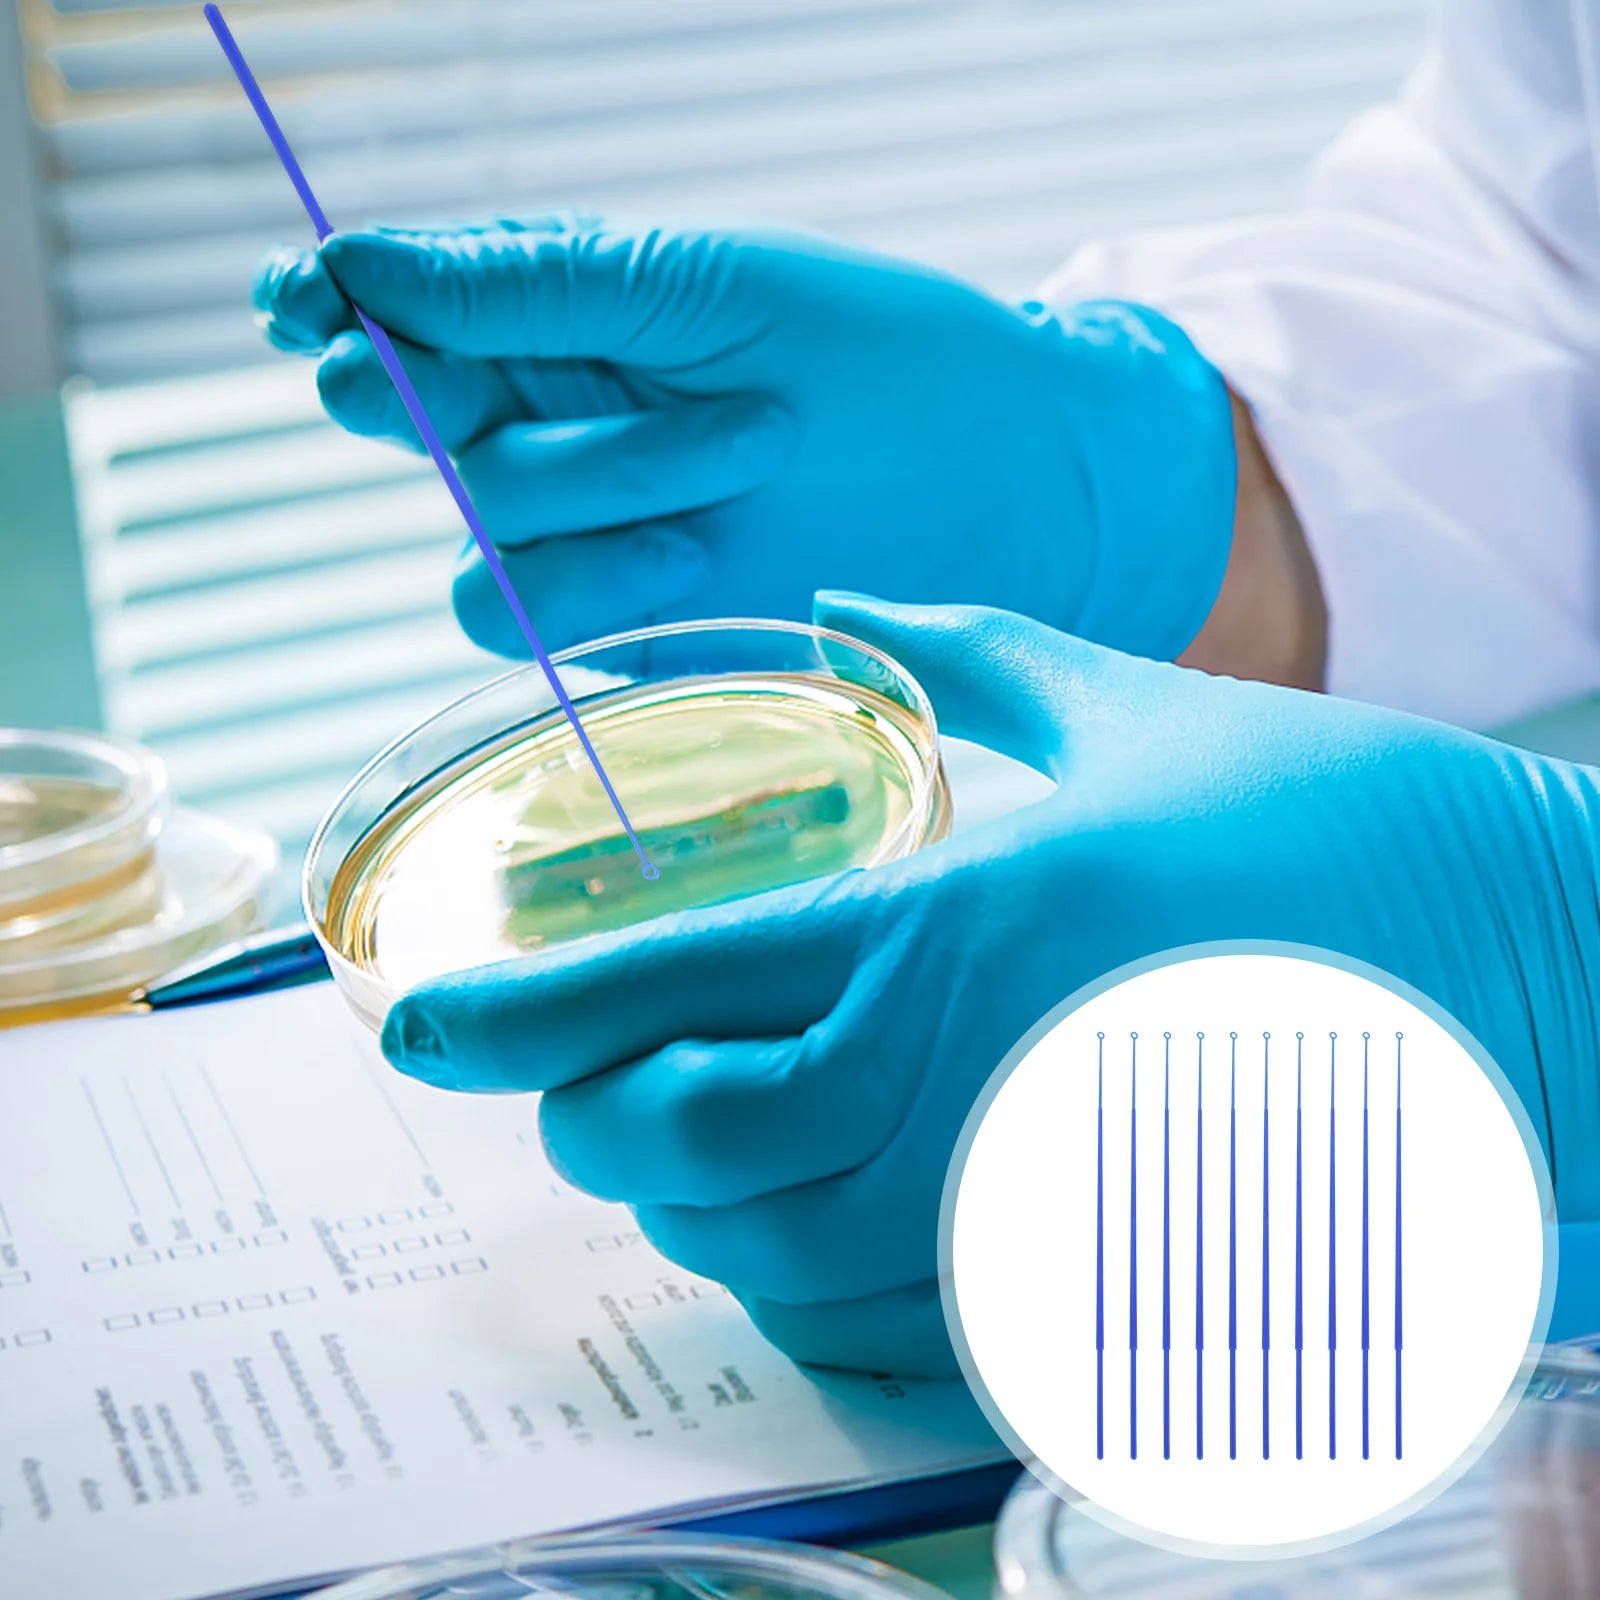
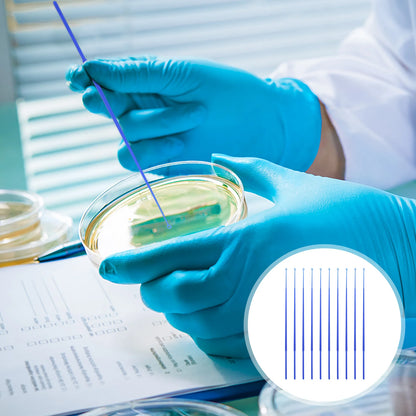
20 Pcs Inoculating Stick Microbiology Inoculation Rods Laboratory Tool Petri Dish Culture Plate Lab Equipment Science Experiment

1
/
of
6
Loading...
20 Pcs Inoculating Stick Microbiology Inoculation Rods Laboratory Tool Petri Dish Culture Plate Lab Equipment Science Experiment
20 Pcs Inoculating Stick Microbiology Inoculation Rods Laboratory Tool Petri Dish Culture Plate Lab Equipment Science Experiment
Regular price
$27.75
Regular price
$27.75
$0.00
Unit price
/
per
Hurry! Offer ends in
Click to copy
SALE10
$24.98
$27.75
Save 10%
Copied! Apply at Checkout
Couldn't load pickup availability
People are viewing right now.
Get it between 8-10 days.
Payment option
Description
Description
SPECIFICATIONS
Brand Name: NoEnName_Null
Choice: yes
High-concerned chemical: None
Origin: Mainland China
feature1: Microbiology Inoculation Rod
feature2: Laboratory Tool
feature3: Laboratory Parts
feature4: Laboratory Tool Supply
feature5: Laboratory Device
semi_Choice: yes
DescriptionThese inoculating loops feature small size and light weight, easy to control the balance and operate in your experiment operation, providing you with simple use. Inoculation loops are made of materials with good stability, heat and corrosion resistance, which can be cleaned at high temperature.
Features
- Color: Blue.
- Material: HIPS.
- Size: 21.50X0.20X0.20cm/8.45X0.08X0.08 inch.
- It is also very simple to replace the inoculating loop, whether it is applied in the laboratory or in the classroom.
- Fine workmanship and great texture, not only stable but also .
- The replacement inoculating rings uses premium material for durability and long-lasting use.
- The perfect workmanship will give you an excellent use experience.
- Adopts precision production to improve the stable characteristics and high reliability.
20 x Inoculation Rods








Benefits
Benefits
Specifications
Specifications
Share






Why Choose Us
-
Secure Checkout
-
100% Satisfaction Guarantee
-
Eco-Friendly Materials.
Flash Sale Alert!
Get FREE Shipping on all products—limited time only!
00
Days
00
Hours
00
Minutes
00
Seconds
-
Limited Time Offer!
-
Exclusive Deal!
-
Free Shipping Alert!